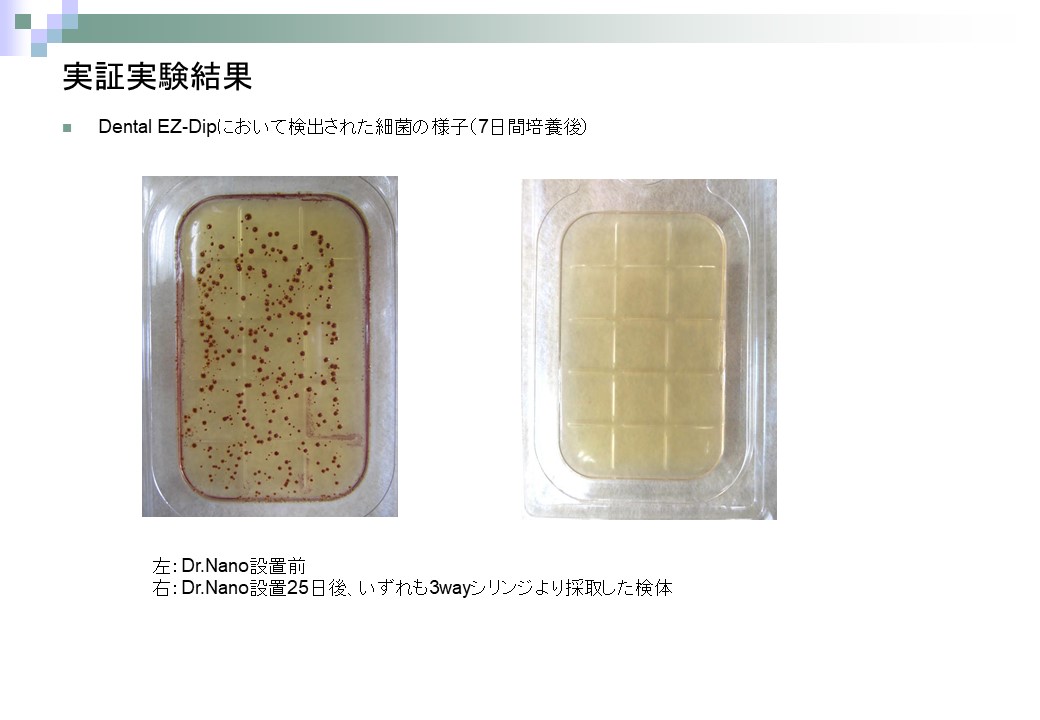

1.論文発表
2019年に日大口腔科学に「ナノバブル水を応用した歯科用チェアユニット給水システムの汚染対策の検討」として論文が発表されました。
2018年の実証比較試験を基に、第三者の目で客観的、学術的に考察いただいています。
3336e4c436d9ea84f16a67f4aceb3be52.実証比較実験
2018年2~3月に、同一歯科医院において、Dr. Nanoを1カ月以上前に付けたユニットと、付けていないユニット(コントロール)から検体を採取し、Dr. Nanoの除菌効果について、比較実験を行いました。
Dr. Nanoを付けていないユニットでは、90%から生菌が検出された一方で、同じ歯科医院の(すなわち同じ水道水を使っている)Dr.Nanoを付けたユニットからは、生菌は検出されませんでした。


3.ナノバブル水のバイオフィルム除去能について
2016年5月に当評議会主任研究員、早稲田大学嘱託研究員の田中正彦が疑似バイオフィルムを使ったナノバブル水の効果測定実験を行いました。
比較可能な複数の均一バイオフィルムを人工的に作ることは困難なため、疑似バイオフィルムとして納豆を使ったユニークな実験です。
nanobable_biofilm4.クリニックでの実証実験
2016年7-9月に予備検査で従属栄養細菌がシリンジから検出された歯科クリニックの2台のユニット(設置後5年以上)に実際にDr. Nanoを取り付けて、従属栄養細菌数と総菌数の変化を調べました。
取付直後から、長年付着したバイオフィルムと思われる黄色の水が排出されました。
最大10,000cfu/ml以上だったものが約1か月後には測定限界以下となりました(従属栄養細菌の暫定基準値2,000CFU cfu/ml)。

5.特許関係
出願中
出願番号: 特開 2019-195386
発明の名称: 歯科ユニット用洗浄水供給装置、歯科ユニット及び歯科ユニットのメンテナンス方法
登録済み
特許番号: 特許第6770276号
発明の名称: 歯科ユニット用洗浄水供給装置及びそれに用いる液体処理ノズル
6.商標登録
出願番号:商願 2016-70931
商標名: 「Dr.Nano」
登録番号:第5929151号
